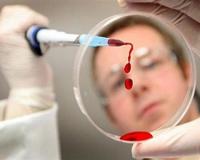
Отдохнувший в Таиланде школьник привез в Хабаровск свиной грипп

Отдохнувший в Таиланде школьник привез в Хабаровск свиной грипп
Как сообщают РИА Новости, хабаровские врачи диагностировали у школьника, вернувшегося из Таиланда, свиной грипп.
Татьяна Каравянская, начальник отдела эпидемиологического
надзора управления Роспотребнадзора по Хабаровскому краю рассказала, что грипп
типа A/H1N1 был выявлен в одном из пунктов пропуска аэропорта Хабаровска.
Сейчас диагноз мальчика уже подтвержден лабораторно.
Медики ведут пристальное наблюдение за состоянием школьника. По словам Каравянской,
в России эта разновидность гриппа присутствует с 2009 года, но в Хабаровском
крае это пока первый зафиксированный случай заболевания.
А накануне стало известно о том, что в Московской
области от этой же разновидности гриппа скончался восьмилетний мальчик.
Окончательный диагноз смерти ребенка уже установлен – мальчик умер в Пушкино от
гриппа A/H1N1.
А вот информацию о смерти от свиного гриппа 11-летней
девочки в Дмитрове Московской области Роспотребнадзор не подтверждает. Об этом
в среду заявил главный санитарный врач РФ Геннадий Онищенко.
В свою очередь Каравянская добавила, что повода для паники нет. Она подчеркнула, что при своевременном обращении к врачам жизни пациентов совершенно ничего не угрожает.
Текст:
Ю. Корвякова

Материалы
сайта могут содержать информацию, не подлежащую просмотру лицам младше 18
лет








